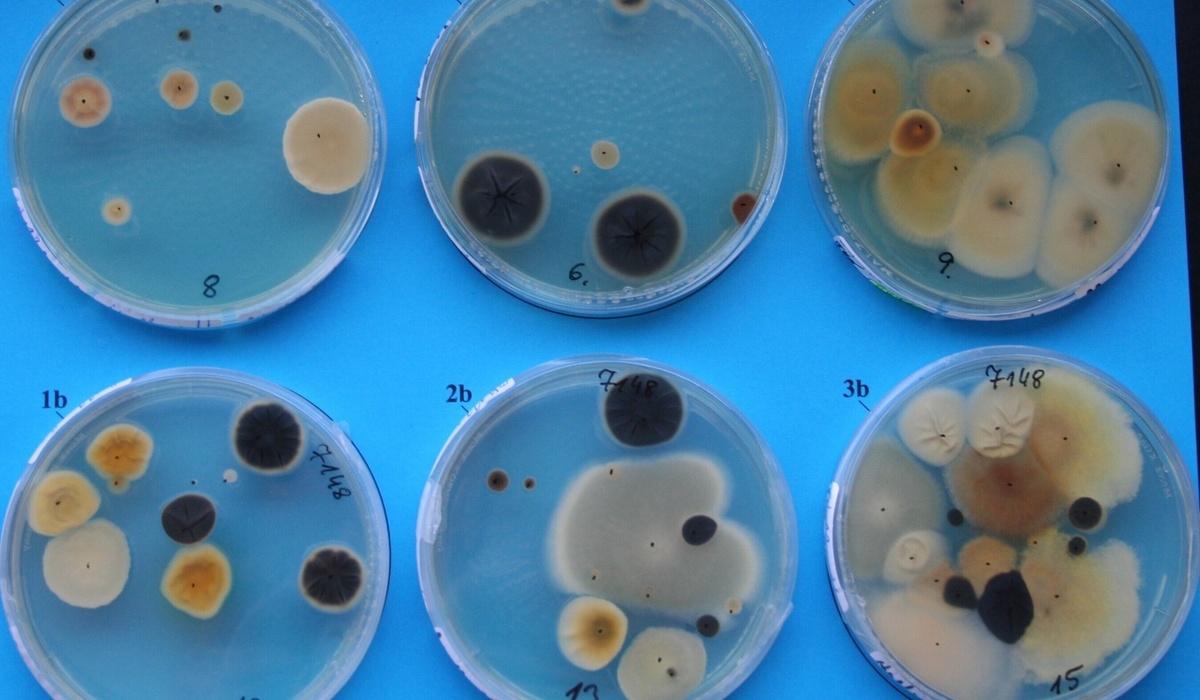
mid Groß-Gerau - Entnommene Kfz-Luftproben auf Nährboden. Tunap

Klimaanlagen-Reinigung für gesunde Luft im Auto
Was bei der Pflege rund um das Auto oft vergessen wird, ist die Wartung und die professionelle Reinigung der Klimaanlage. Der Verein Deutscher Ingenieure (VDI) und der Zentralverband Deutsches Kraftfahrzeuggewerbe (ZDK) haben daher den Hygiene-Standard für Klimaanlagen im Auto neu definiert.